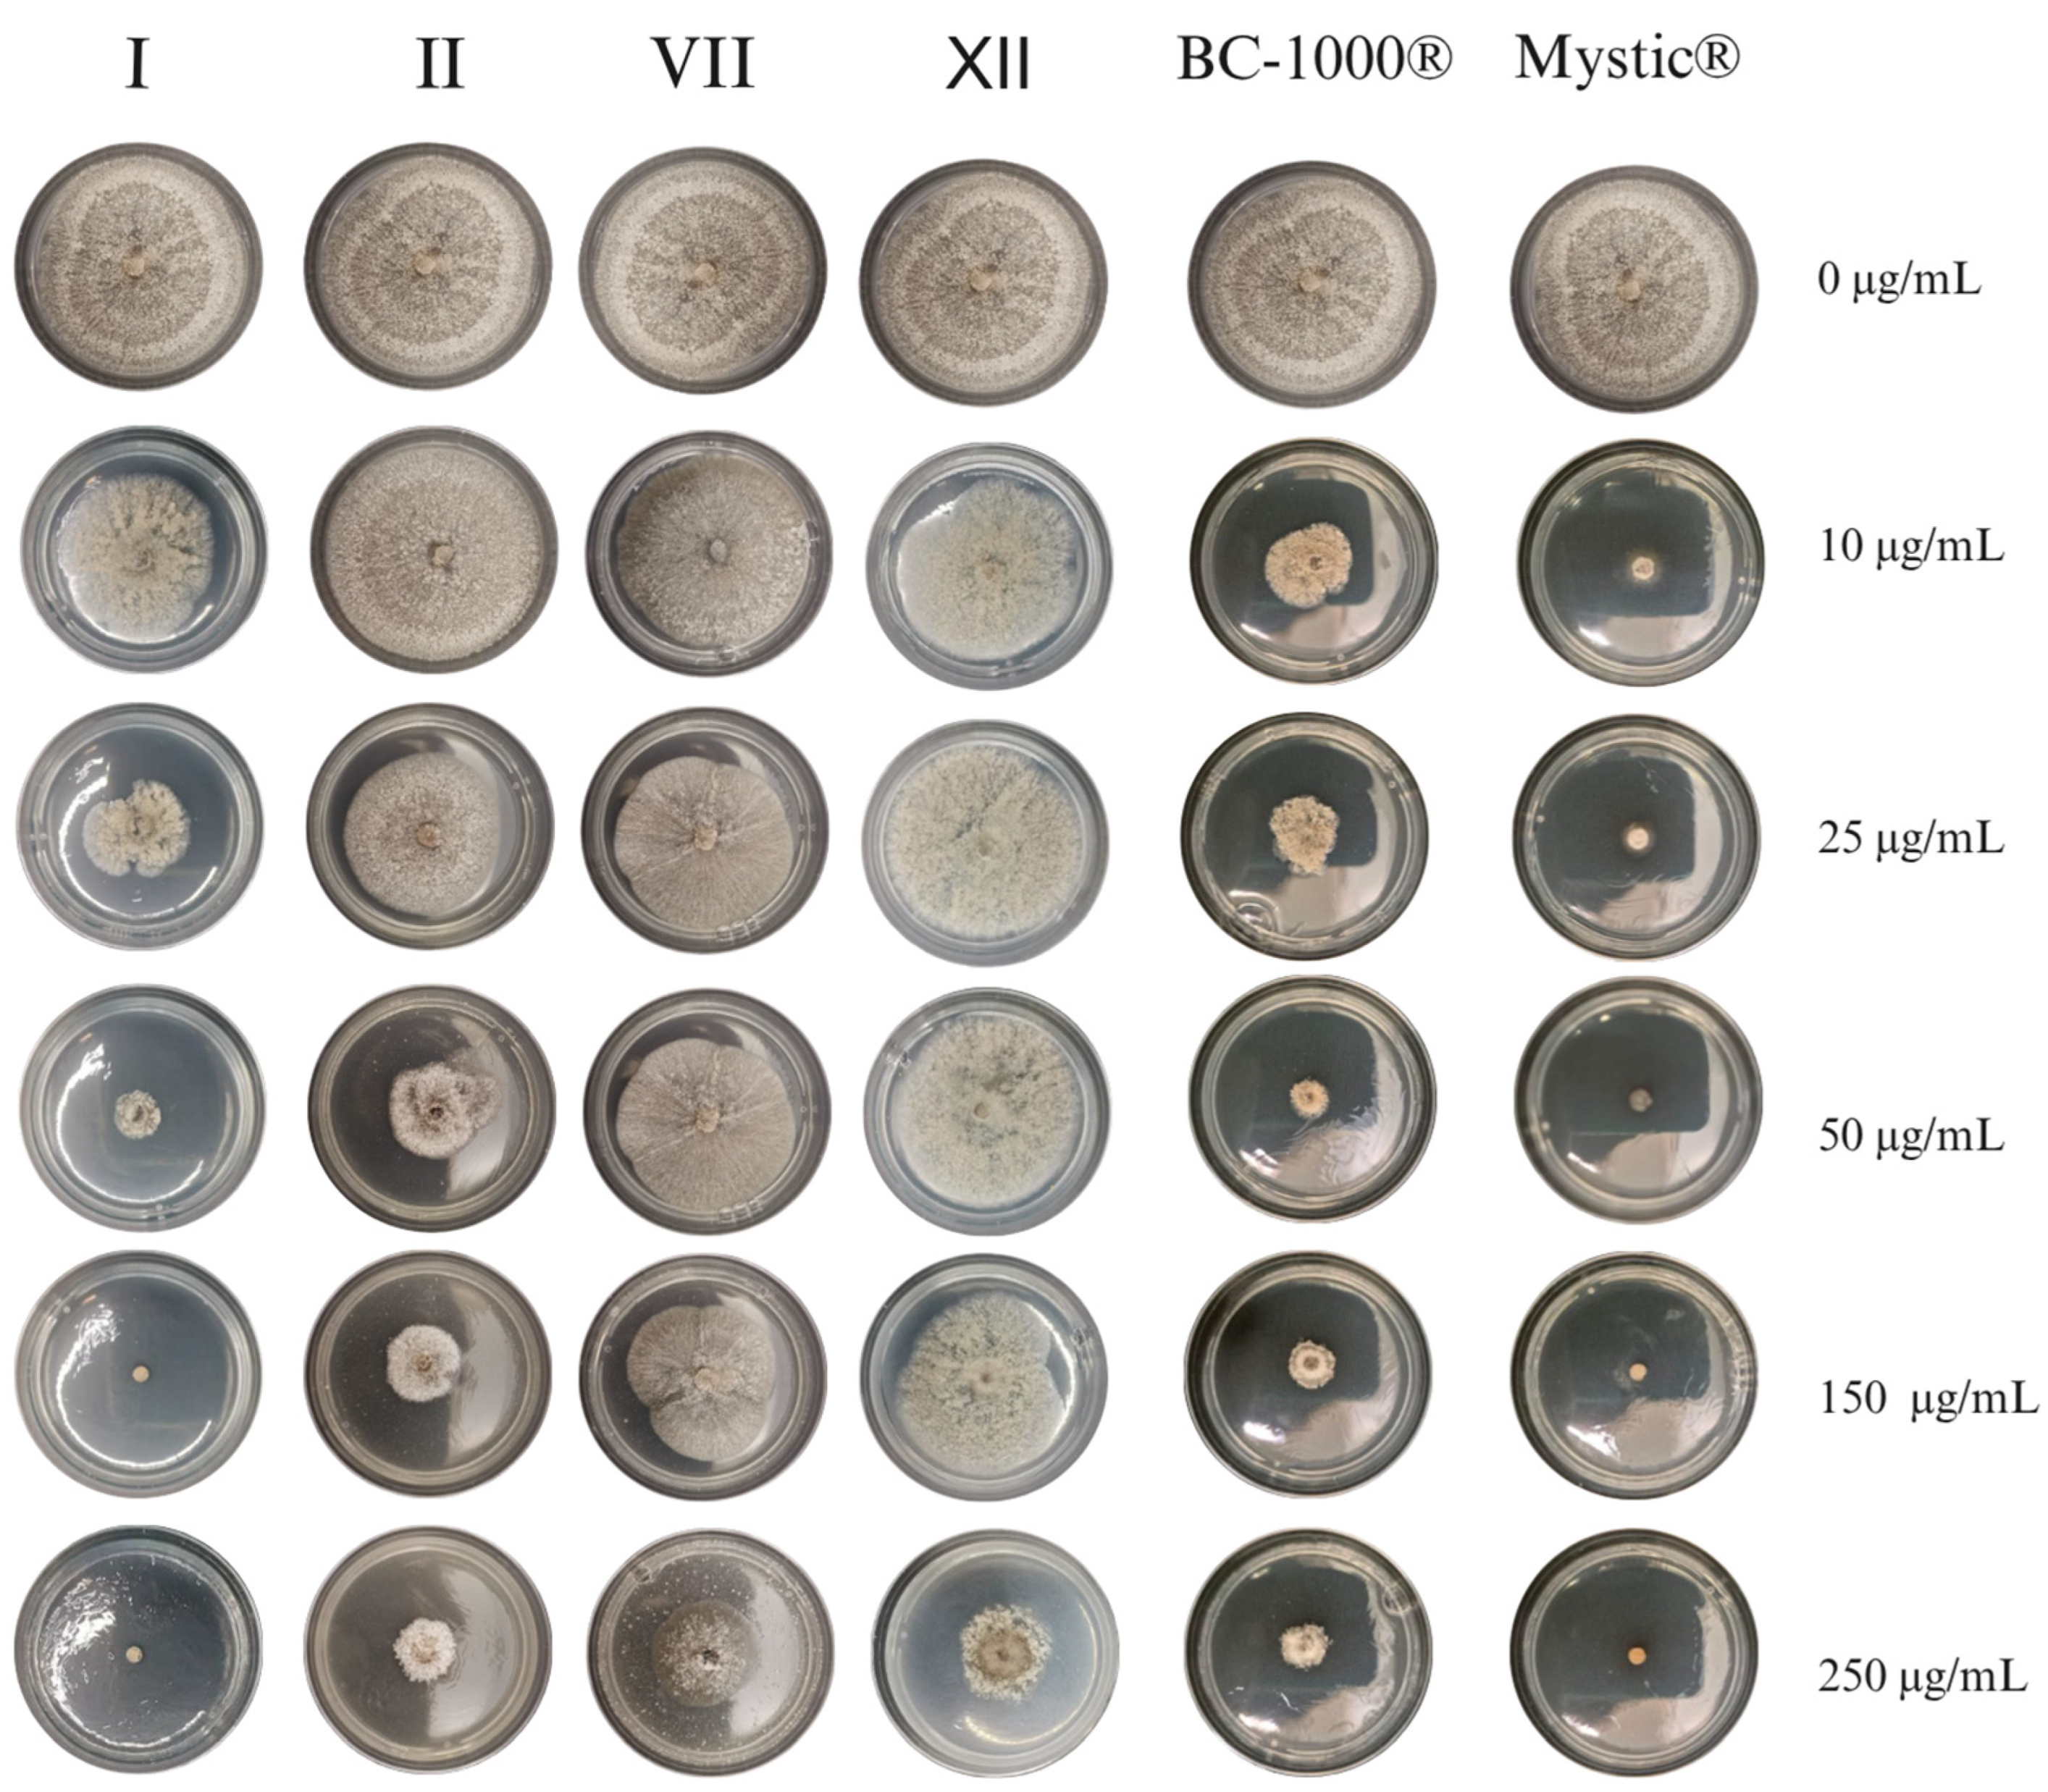
Agronomy 15 02267 g002

Fungicidal Potential of 3-Acyl-6-bromoindole Derivatives: Synthesis, In Vitro Activity, and Molecular Docking Against Botrytis cinerea and Monilinia fructicola
Abstract
1. Introduction
2. Materials and Methods
2.1. Synthesis of 6-Bromo-3-acylindoles
2.2. Antifungal Activity
2.2.1. Strains
2.2.2. Inhibition of Mycelial Growth Assay
2.2.3. Conidial Germination Inhibition Assay
2.3. In Silico Assay
2.3.1. Ligand Preparation
2.3.2. Three-Dimensional Modeling of MfCat2
2.3.3. Active Site Prediction of MfCat2
2.3.4. Structural Validation by Alignment
2.3.5. Preparation of the SDH Receptor
2.3.6. Molecular Docking
3. Results
3.1. Synthesis of Compounds II–XII
3.2. Antifungal Activities of Compounds I–XII
3.3. Molecular Docking
4. Conclusions
Supplementary Materials
Author Contributions
Funding
Data Availability Statement
Acknowledgments
Conflicts of Interest
References
- Yahia, E.M. (Ed.) Classification of Horticultural Commodities. In Postharvest Technology of Perishable Horticultural Commodities; Woodhead Publishing: Cambridge, UK, 2019; Chapter 3; pp. 71–97. [Google Scholar] [CrossRef]
- Cheung, N.; Tian, L.; Liu, X.; Li, X. The Destructive Fungal Pathogen Botrytis cinerea—Insights from Genes Studied with Mutant Analysis. Pathogens 2020, 9, 923. [Google Scholar] [CrossRef]
- Hrustić, J.; Medić, O.; Berić, T.; Mihajlović, M.; Milijašević-Marčić, S.; Stanković, S.; Pešić, B. Suppression of Monilinia Brown Rot by Bacillus spp. Strains. Agronomy 2023, 13, 2839. [Google Scholar] [CrossRef]
- Canessa, P.; Ferrari, S. Editorial: Molecular interactions and control strategies for Botrytis cinerea in crop production. Front Plant Sci. 2025, 16, 1624296. [Google Scholar] [CrossRef] [PubMed]
- Mustafa, M.H.; Bassi, D.; Corre, M.-N.; Lino, L.O.; Signoret, V.; Quilot-Turion, B.; Cirilli, M. Phenotyping Brown Rot Susceptibility in Stone Fruit: A Literature Review with Emphasis on Peach. Horticulturae 2021, 7, 115. [Google Scholar] [CrossRef]
- Garcia-Benitez, C.; Casals, C.; Usall, J.; Sánchez-Ramos, I.; Melgarejo, P.; De Cal, A. Impact of Postharvest Handling on Preharvest Latent Infections Caused by Monilinia spp. in Nectarines. J. Fungi 2020, 6, 266. [Google Scholar] [CrossRef]
- Roca-Couso, R.; Flores-Félix, J.D.; Rivas, R. Mechanisms of Action of Microbial Biocontrol Agents against Botrytis cinerea. J. Fungi 2021, 7, 1045. [Google Scholar] [CrossRef]
- Kgang, I.E.; Klein, A.; Husselmann, L.; Nkomo, A.; Mathabe, P.M.K.; Belay, Z.A.; Caleb, O.J. Bioassays and proteomics as early detection tools in postharvest management of table grapes (Vitis vinifera L.) diseases—A Review. Food Biosci. 2023, 53, 102645. [Google Scholar] [CrossRef]
- Latorre, B.A.; Elfar, K.; Ferrada, E.E. Gray mold caused by Botrytis cinerea limits grape production in Chile. Cienc. Investig. Agrar. 2015, 42, 305–330. [Google Scholar] [CrossRef]
- Uvanova. Available online: https://www.uvanova.cl/articulos/botritis-el-enemigo-numero-uno-de-la-uva-de-mesa/ (accessed on 25 July 2025).
- Smartcherry. Available online: https://smartcherry.cl/manejos-agronomicos/sanidad-vegetal/tizon-de-la-flor-del-cerezo-el-objetivo-del-control-en-floracion/ (accessed on 25 July 2025).
- Wang, G.; Wang, Y.; Wang, K.; Zhao, H.; Liu, M.; Liang, W.; Li, D. Perillaldehyde Functions as a Potential Antifungal Agent by Triggering Metacaspase-Independent Apoptosis in Botrytis cinerea. Microbiol. Spectr. 2023, 11, e00526-23. [Google Scholar] [CrossRef]
- Di Liberto, M.G.; Stegmayer, M.I.; Fernández, L.N.; Quiroga, A.D.; Svetaz, L.A.; Derita, M.G. Control of Brown Rot Produced by Monilinia fructicola in Peaches Using a Full-Spectrum Extract of Zuccagnia punctata Cav. Horticulturae 2023, 9, 1141. [Google Scholar] [CrossRef]
- Tan, Y.; Jiang, Q.; Lin, C.; Fang, Y.; Dai, H.; Tang, B.; Wu, W.; Zheng, S. Synthesis and antifungal activity of novel chiral indole analogues. Nat. Prod. Res. 2022, 37, 2335–2341. [Google Scholar] [CrossRef]
- Zheng, S.; Jiang, Q.; Massande, G.N.; Wu, W.; Lin, C.; Fang, Y.; Tan, Y.; Zhu, R. Synthesis and Antifungal Activity of Indole Derivatives. Chem. Nat. Compd. 2023, 59, 111–118. [Google Scholar] [CrossRef]
- He, B.; Hu, Y.; Mao, P.; Deng, T.; Wang, Y.; Luo, X.; Zou, H.; Wang, Z.; Xue, W. Design, synthesis and antifungal activity of indole derivatives containing 1,3,4-oxadiazole. Arab. J. Chem. 2024, 17, 105758. [Google Scholar] [CrossRef]
- Murcia, C.; Coello, L.; Fernández, R.; Martín, M.J.; Reyes, F.; Francesch, A.; Munt, S.; Cuevas, C. Tanjungides A and B: New Antitumoral Bromoindole Derived Compounds from Diazona cf formosa. Isolation and Total Synthesis. Mar. Drugs 2014, 12, 1116–1130. [Google Scholar] [CrossRef] [PubMed]
- Thanikachalam, P.V.; Maurya, R.K.; Garg, V.; Monga, V. An insight into the medicinal perspective of synthetic analogs of indole: A review. Eur. J. Med. Chem. 2019, 180, 562–612. [Google Scholar] [CrossRef] [PubMed]
- Novikov, R.A.; Platonov, D.N.; Belyy, A.Y.; Potapov, K.V.; Novikov, M.A.; Tomilov, Y.V.; Kechko, O.I.; Seregina, T.A.; Zemskaya, A.S.; Solyev, P.N.; et al. 6-Bromoindole- and 6-Bromoindazole-Based Inhibitors of Bacterial Cystathionine γ-Lyase Containing 3-Aminothiophene-2-Carboxylate Moiety. Molecules 2025, 30, 388. [Google Scholar] [CrossRef]
- Xu, H.; bin Yang, W.; Wang, Q. Antifungal Agents. Part 3: Synthesis and Antifungal Activities of 3-Acylindole Analogs against Phytopathogenic Fungi In Vitro. Chem. Biol. Drug Des. 2011, 78, 864–868. [Google Scholar] [CrossRef]
- Bai, Z.; Dang, K.; Tang, J.; Yang, R.; Fan, L.; Li, Q.; Yang, Y.; Ye, M.; Su, F. Synthesis, Characterization, and Evaluation of the Antifungal Properties of 3-Indolyl-3-Hydroxy Oxindole Derivatives Against Plant Pathogenic Fungi. Molecules 2025, 30, 1079. [Google Scholar] [CrossRef]
- Saravanan, V.; Banerjee, S.; Muthukumaradoss, K.; Deivasigamani, P.; Periyasamy, S. Revolutionizing organic synthesis through green chemistry: Metal-free, bio-based, and microwave-assisted methods. Front. Chem. 2025, 13, 1656935. [Google Scholar] [CrossRef]
- Tran, P.H.; Tran, H.N.; Hansen, P.E.; Do, M.H.N.; Le, T.N. A Simple, Effective, Green Method for the Regioselective 3-Acylation of Unprotected Indoles. Molecules 2015, 20, 19605–19619. [Google Scholar] [CrossRef]
- Borah, A.J.; Shi, Z. Palladium-catalyzed regioselective C–H fluoroalkylation of indoles at the C4-position. ChemComm. 2017, 53, 3945–3948. [Google Scholar] [CrossRef]
- Giblin, G.M.P.; Gibson, M.; Hall, A. Indole Compounds. WO2008006795A3, 9 July 2007. Available online: https://patents.google.com/patent/WO2008006795A3/en (accessed on 18 August 2025).
- Wang, J.B.; Yue, T.; Xu, L.; Hao, Z.Q.; Zhang, Z.H. CdS/Mg–Fe layered double hydroxide: A versatile heterogeneous photocatalyst for the acylation of indoles with α-keto acids. Green Chem. 2024, 26, 12034–12042. [Google Scholar] [CrossRef]
- Wipo. Available online: https://patentscope.wipo.int/search/en/WO2006110638 (accessed on 18 August 2025).
- Nakamura, A.; Tanaka, S.; Imamiya, A.; Takane, R.; Ohta, C.; Fujimura, K.; Maegawa, T.; Miki, Y. Synthesis of 3-acylindoles by oxidative rearrangement of 2-aminochalcones using a hypervalent iodine reagent and cyclization sequence. Org. Biomol. Chem. 2017, 15, 6702–6705. [Google Scholar] [CrossRef]
- Ferreira, C.; Silva, V.; Muñoz, E.; Valle, G.; Martínez-Lobos, M.; Valdés, F.; Díaz, K.; Montenegro, I.; Godoy, P.; Caro, N.; et al. The Effect of 3′,4′-Methylenedioxychalcone Derivatives on Mycelial Growth and Conidial Germination of Monilinia fructicola: An In Silico and In Vitro Study. Agriculture 2025, 15, 983. [Google Scholar] [CrossRef]
- Heravi, M.M.; Zadsirjan, V.; Saedi, P.; Momeni, T. Applications of Friedel-Crafts reactions in total synthesis of natural products. RSC Adv. 2018, 8, 40061–40163. [Google Scholar] [CrossRef] [PubMed]
- Porwal, A.; Rajendiran, A.; Alam, P.; Singh, H.; Singh, K.; Dubey, A. Indole Moiety in Organic Synthesis: A Comprehensive Review of Methods and Mechanisms. Int. J. Pharm. Investig. 2024, 14, 1052–1060. [Google Scholar] [CrossRef]
- Ahmad, T.; Khan, S.; Ullah, N. Recent Advances in the Catalytic Asymmetric Friedel-Crafts Reactions of Indoles. ACS Omega 2022, 7, 35446–35485. [Google Scholar] [CrossRef] [PubMed]
- Maity, P.; Mitra, A.K. Ionic Liquid-Assisted Approaches in the Synthesis of Nitrogen-Containing Heterocycles: A Focus on 3-to 6-Membered Rings. J. Ionic Liq. 2025, 5, 100146. [Google Scholar] [CrossRef]
- Zhang, Y.Y.; Li, L.; Zhang, X.Z.; Peng, J.B. Brønsted acid catalyzed remote C6 functionalization of 2, 3-disubstituted indoles with β, γ-unsaturated α-ketoester. Front Chem. 2022, 10, 992398. [Google Scholar] [CrossRef]
- Sun, P.; Huang, Y.; Chen, S.; Ma, X.; Yang, Z.; Wu, J. Indole derivatives as agrochemicals: An overview. Chin. Chem. Lett. 2024, 35, 109005. [Google Scholar] [CrossRef]
- Jeschke, P. Manufacturing approaches of new halogenated agrochemicals. Eur. J. Org. Chem. 2022, 2022, e202101513. [Google Scholar] [CrossRef]
- Campana, R.; Favi, G.; Baffone, W.; Lucarini, S. Marine Alkaloid 2,2-Bis(6-bromo-3-indolyl) Ethylamine and Its Synthetic Derivatives Inhibit Microbial Biofilms Formation and Disaggregate Developed Biofilms. Microorganisms 2019, 7, 28. [Google Scholar] [CrossRef]
- Manoharan, R.K.; Lee, J.H.; Lee, J. Efficacy of 7-benzyloxyindole and other halogenated indoles to inhibit Candida albicans biofilm and hyphal formation. Microb. Biotechnol. 2018, 11, 1060–1069. [Google Scholar] [CrossRef]
- Ortiz, S.C.; Huang, M.; Hull, C.M. Spore germination as a target for antifungal therapeutics. Antimicrob. Agents Chemother. 2019, 63, 10–1128. [Google Scholar] [CrossRef]
- Madrid, A.; Silva, V.; Reyes, C.; Werner, E.; Besoain, X.; Montenegro, I.; Muñoz, E.; Díaz, K. Control of Peach Brown Rot Disease Produced by Monilinia fructicola and Monilinia laxa Using Benzylidene-Cycloalkanones. J. Fungi 2024, 10, 609. [Google Scholar] [CrossRef] [PubMed]
- Fraaije, B.A.; Bayon, C.; Atkins, S.; Cools, H.J.; Lucas, J.A.; Fraaije, M.W. Risk Assessment Studies on Succinate Dehydrogenase Inhibitors by Analysis of the Succinate Dehydrogenase Genes of Mycosphaerella graminicola. Mol. Plant Pathol. 2011, 13, 64–75. [Google Scholar] [CrossRef]
- Chen, S.; Yang, H.; Chen, M.; Liu, W.; Tian, S.; Mu, R.; Jia, F.; Liu, C.; Ma, G.; Sun, X.; et al. Inhibition of Monilinia fructicola sporulation and pathogenicity through eucalyptol-mediated targeting of MfCat2 by Streptomyces lincolnensis strain JCP1-7. Mol. Plant Pathol. 2024, 25, e13484. [Google Scholar] [CrossRef] [PubMed]
- He, B.; Hu, Y.; Chen, W.; He, X.; Zhang, E.; Hu, M.; Zhang, P.; Yan, W.; Ye, Y. Design, Synthesis, and Antifungal Activity of N-(alkoxy)-Diphenyl Ether Carboxamide Derivates as Novel Succinate Dehydrogenase Inhibitors. Molecules 2024, 29, 83. [Google Scholar] [CrossRef]
- McPherson, A. Triclinic Crystal Form of Beef Liver Catalase at 1.85 Å Resolution. Available online: https://www.wwpdb.org/pdb?id=pdb_00006pm7 (accessed on 20 July 2025).
- Park, J.; Son, H. Antioxidant systems of plant pathogenic fungi: Functions in oxidative stress response and their regulatory mechanisms. Plant Pathol. J. 2024, 40, 235. [Google Scholar] [CrossRef]
- Ding, J.L.; Li, X.H.; Lei, J.H.; Feng, M.G.; Ying, S.H. Succinate Dehydrogenase Subunit C Contributes to Mycelial Growth and Development, Stress Response, and Virulence in the Insect Parasitic Fungus Beauveria bassiana. Microbiol. Spectr. 2022, 10, e0289122. [Google Scholar] [CrossRef]

| Compound | B. cinerea | M. fructicola | ||
|---|---|---|---|---|
| EC50 (µg/mL) | ICG (%) | EC50 (µg/mL) | ICG (%) | |
| I | 11.62 ± 0.05 | 7 | 18.84 ± 0.23 | 0 |
| II | 98.42 ± 0.68 | 100 | 31.78 ± 0.40 | 96 |
| III | >250 | NI | >250 | NI |
| IV | >250 | NI | >250 | NI |
| V | 179.00 ± 0.81 | 39 | >250 | NI |
| VI | >250 | NI | >250 | NI |
| VII | >250 | NI | 113.97 ± 0.71 | 37 |
| VIII | >250 | NI | >250 | NI |
| IX | >250 | NI | >250 | NI |
| X | >250 | NI | >250 | NI |
| XI | >250 | NI | >250 | NI |
| XII | >250 | NI | 182.23 ± 0.81 | 0 |
| BC-1000® | 95.13 ± 0.67 | 100 | <10 | 84 |
| Captan® | 82.89 ± 0.69 | 100 | - | - |
| Mystic® 520 SC | - | - | <10 | 85 |
| Compound | Binding Energy on SDH kcal/mol | Binding Energy on MfCat2 kcal/mol |
|---|---|---|
| I | −8.960 | −8.789 |
| II | −8.808 | −9.722 |
| III | −8.031 | −8.481 |
| IV | −8.086 | −8.023 |
| V | −8.076 | −8.575 |
| VI | −8.722 | −9.578 |
| VII | −8.540 | −9.313 |
| VIII | −7.789 | −8.799 |
| IX | −8.089 | −8.308 |
| X | −8.037 | −8.589 |
| XI | −8.090 | −8.533 |
| XII | −8.008 | −8.683 |
Disclaimer/Publisher’s Note: The statements, opinions and data contained in all publications are solely those of the individual author(s) and contributor(s) and not of MDPI and/or the editor(s). MDPI and/or the editor(s) disclaim responsibility for any injury to people or property resulting from any ideas, methods, instructions or products referred to in the content. |
© 2025 by the authors. Licensee MDPI, Basel, Switzerland. This article is an open access article distributed under the terms and conditions of the Creative Commons Attribution (CC BY) license (https://creativecommons.org/licenses/by/4.0/).
Share and Cite
Muñoz, E.; Díaz, K.; Montenegro, I.; Caro, N.; Reyes, C.; Silva, V.; Madrid, A. Fungicidal Potential of 3-Acyl-6-bromoindole Derivatives: Synthesis, In Vitro Activity, and Molecular Docking Against Botrytis cinerea and Monilinia fructicola. Agronomy 2025, 15, 2267. https://doi.org/10.3390/agronomy15102267
Muñoz E, Díaz K, Montenegro I, Caro N, Reyes C, Silva V, Madrid A. Fungicidal Potential of 3-Acyl-6-bromoindole Derivatives: Synthesis, In Vitro Activity, and Molecular Docking Against Botrytis cinerea and Monilinia fructicola. Agronomy. 2025; 15(10):2267. https://doi.org/10.3390/agronomy15102267
Chicago/Turabian StyleMuñoz, Evelyn, Katy Díaz, Iván Montenegro, Nelson Caro, Constanza Reyes, Valentina Silva, and Alejandro Madrid. 2025. "Fungicidal Potential of 3-Acyl-6-bromoindole Derivatives: Synthesis, In Vitro Activity, and Molecular Docking Against Botrytis cinerea and Monilinia fructicola" Agronomy 15, no. 10: 2267. https://doi.org/10.3390/agronomy15102267
APA StyleMuñoz, E., Díaz, K., Montenegro, I., Caro, N., Reyes, C., Silva, V., & Madrid, A. (2025). Fungicidal Potential of 3-Acyl-6-bromoindole Derivatives: Synthesis, In Vitro Activity, and Molecular Docking Against Botrytis cinerea and Monilinia fructicola. Agronomy, 15(10), 2267. https://doi.org/10.3390/agronomy15102267

